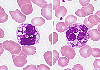

|    |

全登録症例数:225
全登録画像数:1755
全登録画像数:1755
本例は顆粒球系の特徴的な顆粒異常(巨大化)が特徴的であった。臨床的には生下時の易感染性や入院時の部分的白子症などから先天性機能異常であるChediak-Higashi症候群と診断された。これらの巨大顆粒はライソゾ...
(続きを読む) 本例は顆粒球系の特徴的な顆粒異常(巨大化)が特徴的であった。臨床的には生下時の易感染性や入院時の部分的白子症などから先天性機能異常であるChediak-Higashi症候群と診断された。これらの巨大顆粒はライソゾームの巨大化によるもので、顆粒球系の遊走障害、脱顆粒障害を生じ易感染性を呈する原因とされる。
(たたむ)
(続きを読む) 本例は顆粒球系の特徴的な顆粒異常(巨大化)が特徴的であった。臨床的には生下時の易感染性や入院時の部分的白子症などから先天性機能異常であるChediak-Higashi症候群と診断された。これらの巨大顆粒はライソゾームの巨大化によるもので、顆粒球系の遊走障害、脱顆粒障害を生じ易感染性を呈する原因とされる。
(たたむ)
■症例詳細データ
| 性別 | 男 |
|---|---|
| 年齢 | 05-09 |
| 取得年代 | 2000-2004 |
| 主訴 | 日光過敏症、部分的白子症 |
| 既往歴 | 生下時より易感染性あり |
| 現病歴 | 白髪、中耳炎(易感染性)、部分的白子症(皮膚・毛髪・眼) |
| 検査所見 | WBC5,500/μl(St2,Seg32,Eo2,Ba1,Ly44,Mo17,At.ly2%)、RBC438万/μl、Hb 11.8g/dl、Ht35.9%、MCV82.0fl、MCH26.9pg、MCHC32.8%、PLT25.8万/μl、NCC21.5万/μl、TP6.4g/dl, AST21IU/l, ALT13IU/l, LDH302IU/l、CRP1.6mg/dl |
| 末梢血所見 | 白血球細胞の細胞質に異常所見を認める。顆粒球系(好中球・好酸球・好塩基球)には低顆粒や顆粒の巨大化、リンパ球には円形状の青紫色の封入体、単球の一部には貪食もしくは封入体らしきものがみられた。他に僅かであるが巨大血小板がみられた。 |
| 骨髄所見 | 正形成の骨髄にて、顆粒球系に幼若から成熟型にかけ脱顆粒や巨大顆粒がみられ、末梢血と同じような所見であった。顆粒の色調は青紫色から濃灰色と多様であった。 |
| 細胞化学所見 | PO染色では顆粒系全般に顆粒が出現しているあたりに陽性がみられた。 |
| 形態診断 | 形態学的には顆粒球系に脱顆粒と巨大顆粒の出現またリンパ球に封入体を認めた。臨床的には部分的白子症などを認めたことよりChediak-Higashi症候群を疑った。 |
| 免疫学的所見 | N.D |
| 分子生物学的所見 | 46,XY |
| リンパ節所見 | N.D |
| 臨床診断 | 顆粒球系の特徴的な顆粒異常(巨大化)が特徴的であった。臨床的には生下時の易感染性や入院時の部分的白子症などから先天性機能異常であるChediak-Higashi症候群と診断された。これらの巨大顆粒はライソゾームの巨大化によるもので、顆粒球系の遊走障害、脱顆粒障害を生じ易感染性を呈する原因とされる。 |